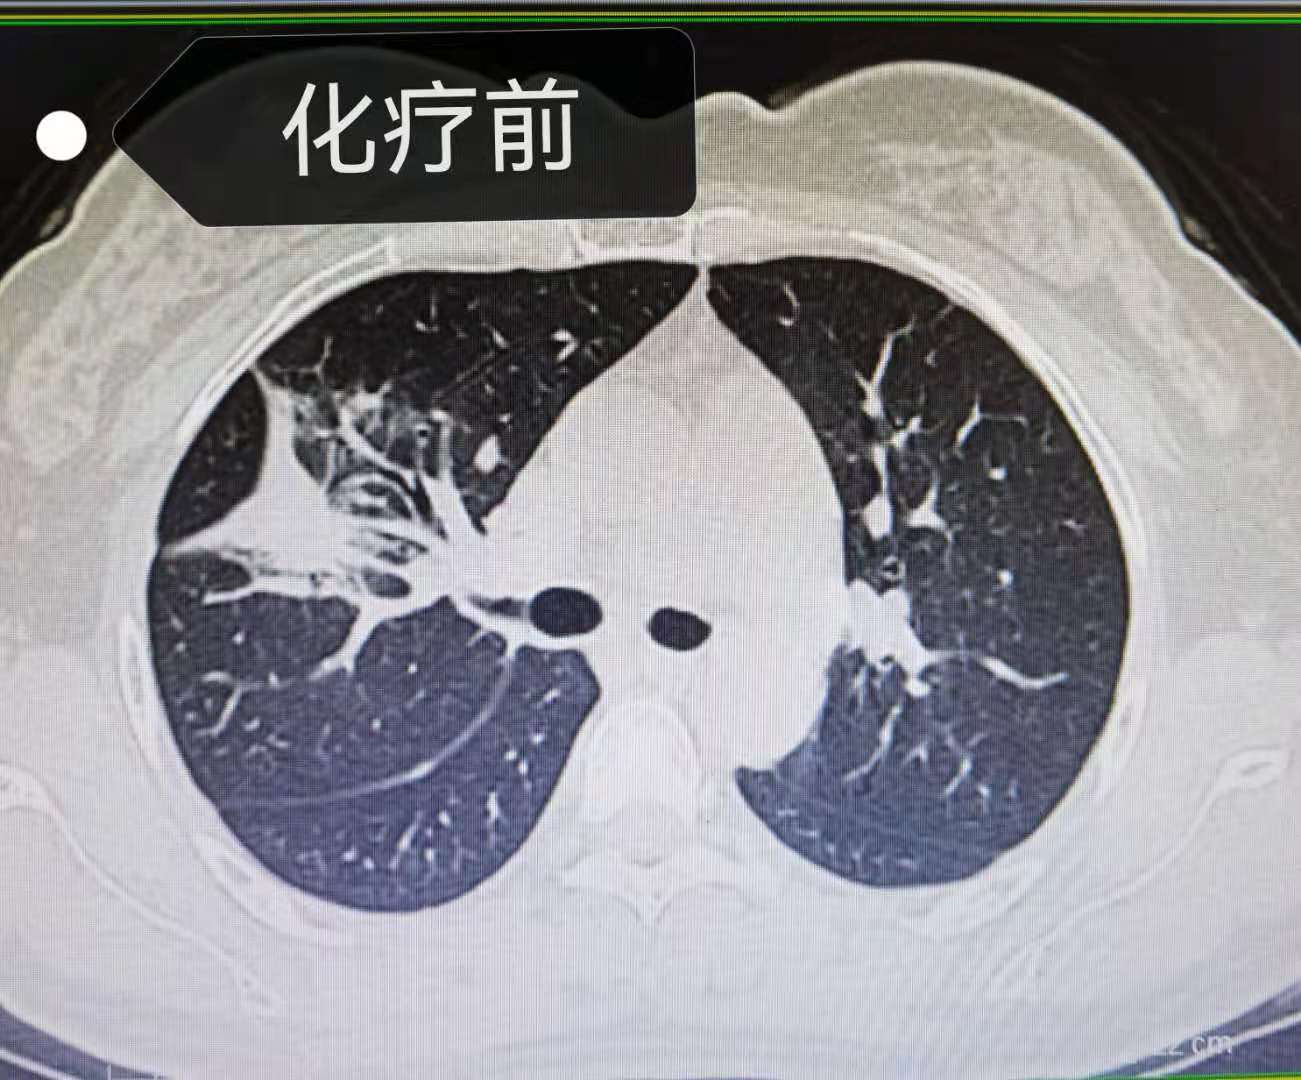
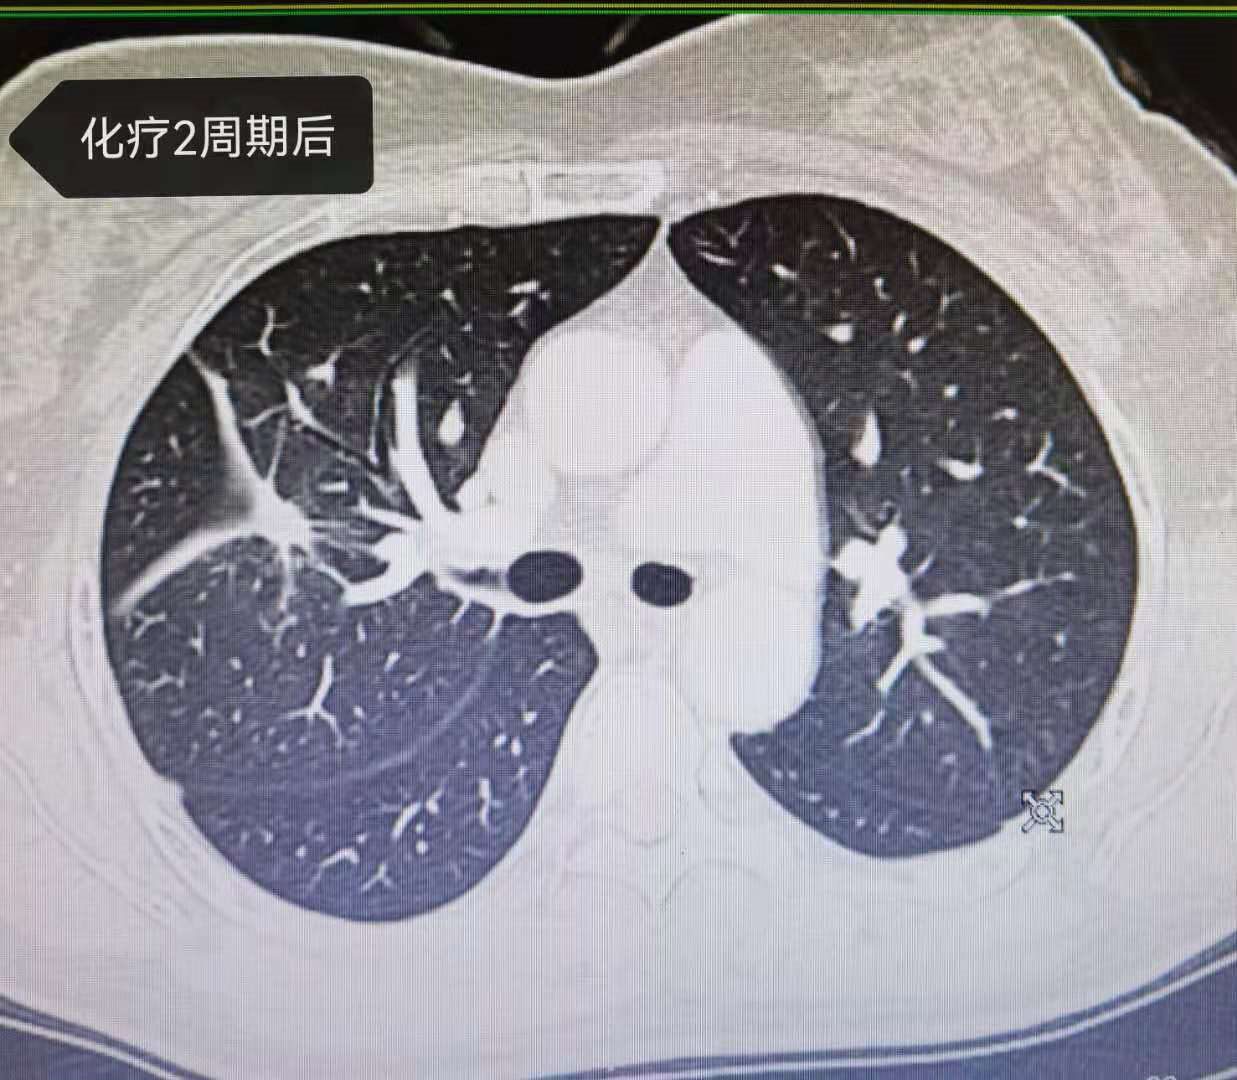

用户_胡洋|靶向耐药,45岁晚期肺癌病人使用化疗联合抗血管生成药物效果显著!

文章图片
【用户_胡洋|靶向耐药,45岁晚期肺癌病人使用化疗联合抗血管生成药物效果显著!】
文章图片
文章图片

文章图片
金某 , 女性 , 45岁 , 2020年08月体检发现右上肺占位 , 行PET-CT检查 , 提示:右肺上叶前段分叶状软组织肿块 , 边缘毛刺 , 邻近胸膜牵拉 , FDG代谢增高;右侧胸膜结节样增厚 , FDG代谢增高;气管前腔静脉后、主肺动脉窗、右肺门多发肿大淋巴结 , 考虑转移 。 见图1
2020年09月行肺穿刺活检 , 病理提示:(右上肺穿刺)低分化腺癌 。 免疫组化:CK-Pan(++) , CK7(+)TTF-1(++)CK5/6(散+) , Ki-67(约70%) 。 基因检测提示:EGFR 21L858R突变 。 见图2
患者确诊后开始口服三代靶向药奥西替尼 , 很可惜 , 5个月就出现耐药 。 建议更换二代靶向药达克替尼 , 但因经济原因 , 未考虑 。 于是 , 选择了医保能报销的较为经济的方案 , 培美曲塞联合卡铂及安维汀 。 经过4周期化疗 , 患者病灶显著缩小 , 疗效显著 。 见图3、4、5、6、7、8
既往研究显示 , 对于敏感基因突变的病人 , 免疫治疗疗效不佳 , 当靶向治疗耐药后 , 可以考虑化疗联合抗血管生成治疗 。 2015年 , 贝伐珠单抗在我国获批肺癌适应症 , 用于晚期、转移性或复发性非鳞非小细胞肺癌的一线治疗 。 通过结合VEGF使VEGFR丧失活化的机会 , 进而抑制新生肿瘤血管生成 , 起到持续抗肿瘤作用 。
研究显示:接受贝伐珠单抗联合治疗的患者较接受单独化疗患者 , 疾病进展风险降低60% , 死亡风险降低32% 。 无论是NCCN指南、ESMO指南还是CSCO指南 , 贝伐珠单抗都被推荐作为一线用药联合标准方案用于非小细胞肺癌 。
经验总结扩展阅读
- 用户「众测研究团」谁也逃不过真人实测!400人实测霓姿多功能美容仪
- 用户Kanebo嘉娜宝黑管洗面奶怎么样?
- 用户珂润控油保湿啫喱乳液用户测评
- 品牌浪潮产品奖:戴可思—创新应该解决用户的真需求
- 观点评论曼瑜天雅从创立到全球900万用户只用了3年
- 用户一半蜜糖一半伤,2022如何踩准轻医美风口?
- 用户日本帕妃雯保湿面霜用户测评
- 品牌上美不忘初心聚焦用户 韩束荣膺“最具影响力品牌大奖”
- 植物黛珂植物欣韵柔润洁肤霜用户测评
- 用户医美机构直播做自己IP的重要性









